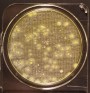
Compact Dry SA
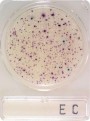
Compact Dry EC

Produse medicale - pagina 26
Compact Dry SA
Mediu de cultura turnat pe placa, in forma deshidratata. Se utilizeaza la detectia S. aureus din mostre de mediu (teste de sanitatie), alimentare sau...
Compact Dry CF
Mediu de cultura turnat pe placa, in forma deshidratata. Se utilizeaza la detectie si numararebacterii coliforme din mostre de mediu (teste de sanitatie), alimentare...
Compact Dry EC
Mediu de cultura turnat pe placa, in forma deshidratata. Se utilizeaza la detectie si numarare bacterii coliforme si E coli din mostre de mediu...
Balanta analitica 210 sau 250 grame
Balanta analitica 210 sau 250 grame si 0.0001 grame rezolutie. Fabricatie Anglia, marcaj CE si ISO 9001. Model PW 124 Capacitate maxima 120 g...
Balanta analitica 120 grame
Balanta analitica 120 grame si 0.0001 grame rezolutie. Fabricatie Anglia, marcaj CE si ISO 9001. Model PW 124 Capacitate maxima 120 g Rezolutie 0.0001g...
Sterilizator autoclav
Simplitatea in manipulare defineste cele doua versiuni de autoclave, de 11 litri si de 22 litri. Cinci programe: 4 pentru sterilizare si 1...
Urocultor cu acid boric, PS sau PP
Urocultor plastic, steril, cu eticheta pentru inscriere date. Centrifugabil.
Burete recoltare pentru mostre mediu
Ansamblu burete steril + punga recoltare + manusi sterile + 10 ml solutie buffer, pentru determinare grad sanitatie suprafete de lucru, carcasa animala, echipament...
Tampon exudat
Tampon steril de unica folosinta pentru prelevare mostre medicale sau mostre mediu pentru determinare grad sanitatie.
Coprorecoltor fara mediu de transport
Coprorecoltor cu baza conica, fusta sprijin pozitie verticala si lingurita, 28 ml capacitate, steril, cu eticheta date. Fabricatie Franta, marcaj CE si ISO 9001.